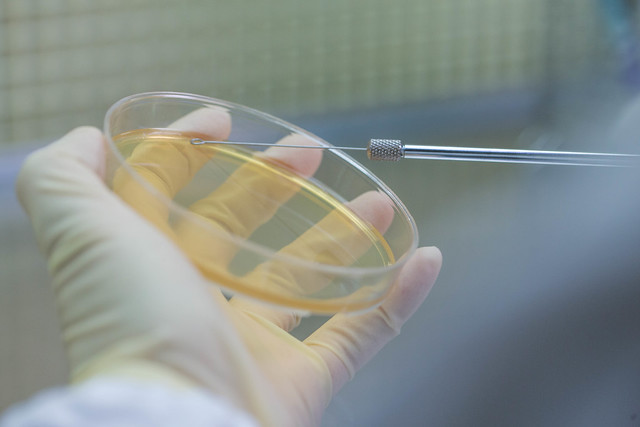
耐受性試驗

「你今天腸胃鬧脾氣了嗎?」根據台灣營養基金會統計,全台超過525萬人口有不順暢的困擾,因為現代人生活步調快、工作壓力大,經常沒辦法好好吃頓飯;尤其外食機會多,常常為了紓壓,不但正餐喜歡重口味,飯後還需要手搖飲跟甜食,加上農曆年剛過,親友聚餐難免大吃大喝,無形中也加重身體負擔,這時候益生菌就可以派上用場了,研究顯示:補充益生菌不但可以改變細菌叢生態、也可使排便順暢、有助調節生理機能。
7大黃金準則挑選有效益生菌

走慢一點,吃暖一點,笑多一點,健康就在你身邊。身體會記得你善待它的每一刻!請點我👉免費加入「早安健康LINE」👈讓我們帶著你一起越變越健康!
如果你正在考慮吃益生菌或已經吃了,不妨多花些時間了解才會吃的事半功倍。市面上益生菌的種類多如繁星,琳瑯滿目的產品,該怎麼選、怎麼吃,才能達到最佳功效?
- 是否具備身分證的益生菌菌株?
不僅要挑菌種,還需要具有編號,才是好的益生菌。因為編號就代表著益生菌的身分證。 - 是否符合食品法規或國際公認安全菌種?
益生菌的安全性非常重要,看看是不是歐盟QPS列表、台灣微生物列表的益生菌。 - 是否具有相關耐受性試驗?
由於益生菌是微生物,舉凡高濕度、高溫度或在空氣中曝露都不利於菌株長期存活,為了能讓益生菌能順利通過胃酸及膽鹼的考驗,安全附著於腸道內,因此建議要選擇擁有專利包覆技術(例如SYNTEK®-MatriCoat技術),才能發揮益生菌最大效益。 - 產品包裝是否標示「菌數」?
建議總菌數每包至少要有20~100億菌數以上,才能吃的「有感」。 - 是否使用優化的包裝技術?
益生菌對於外界環境影響十分敏感,嚴格控管包裝環境中的溫溼度與產品水分和水活性,有助於菌數的穩定與活性的維持。 - 製造廠是否具備國際食品安全系統的認證背書?
為了確保益生菌產品的安全性,從原料品質、生產環境、包裝、倉儲、運輸等過程都需加嚴格管控每一個生產環節。例如FSSC22000、美國NSF-GMP、ISO22000、HACCP、HALAL等。 - 是否有產品監測報告?
除了製造廠的資質認證之外,提供菌數、塑化劑、微生物、重金屬等產品檢驗報告方能確保益生菌產品最終的存活率與安全性。

雖然並不是每個益生菌品牌都可以查詢到以上7項資訊,不過好的產品一定會標示清楚所有的資訊,消費者選購時不妨注意一下!
4個好習慣這樣吃才有感
益生菌餐前吃?餐後吃?包覆技術是關鍵。
- 一般益生菌可在餐中或飯後食用,原因是益生菌比較怕被胃酸、膽鹼破壞,而飯後30分鐘胃酸的濃度較低,或進餐時間食物稀釋胃酸濃度,都是能提高益生菌在人體內的存活比例。
- 不過如果益生菌的包覆技術強,能耐胃酸、耐膽鹼,可於餐前或空腹食用。
- 避開這些食物與藥物
食用益生菌應避免抗生素同時服用,兩者建議避開2~3小時以上。 - 讓益生菌加分的食物
若要加強益生菌的活性與數量,應經常攝取富含膳食纖維及果寡糖的食物,如:深綠色蔬菜、香蕉、全穀類等,幫助益生菌在腸道的繁殖。
SYNPACK®-給益生菌最舒適的家
生合生物提供一項複合性專業技術服務—SYNPACK®優異包裝技術,以「保證菌數」為主軸,精準調控益生菌配方和嚴格控管關鍵指標,保證產品有效期限24個月內的活菌數,大幅提升產品品質,提供有價值、有功效的益生菌產品。
- 專業配方師團隊: 針對市場及需求調控產品的黃金比例配方,並進行安全性、穩定性、功效性評估
- 益生菌優化包裝技術:嚴格控管包裝生產環境的溫溼度與產品水活性,提升益生菌的穩定性。
- 保證菌數:產線全程具有68道監控點,嚴格管控製造流程,保證益生菌產品24個月有效期限內的活菌數,從出廠至貨架期的菌數皆在掌控內。
SYNPACK®三大特點:
- 有團隊,才有好配方
- 有能力,才有好包裝
- 有技術,才敢作保證
關鍵字:
延伸閱讀
繼續閱讀下一篇推薦文章
